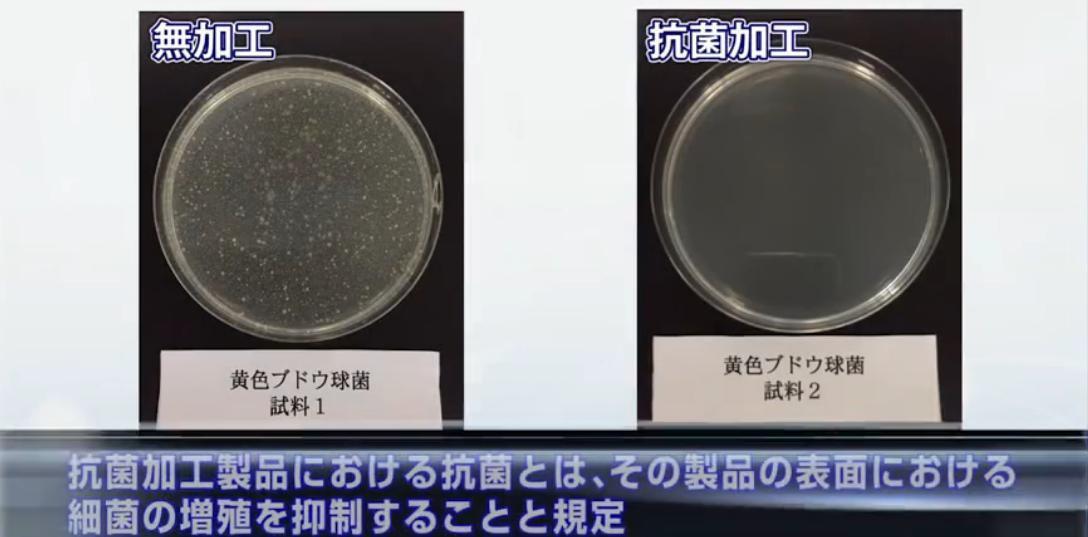

伊耐斯衛浴有限公司



INAX 保溫地磚
THERMOTILE


磁磚會保溫?



![]()
伊耐斯衛浴有限公司





磁磚會保溫?



適用於浴室和洗手間的---保溫地磚 通過降低瓷磚的熱通量(熱量傳遞的速度),腳部不容易感到寒冷。





與傳統瓷磚相比,通過減少熱通量(熱量傳遞的速度),
減少了從腳部散發的熱量,因而難以感覺到寒冷。

因為沒有熱量的傳導,當觸摸到物品時,會感到寒冷。
與保溫磚相比,傳統磚的熱通量(傳熱速度)更大,從腳 部帶走的熱量也更多,因此容易感覺到冷。




將一般地磚放在左腳下,保溫地磚放在右腳下,預定時間,雙腳放在椅子上,用熱像儀拍照。







為什麼我們需要保溫地磚?

腳暖身就暖!萬病起於足底寒
我們身體有六大經脈起源於腳,中醫認為足部是全身最容易受寒的部位,
一旦腳底受寒,就容易造成免疫力下降,導致感冒等疾病的發作,足部
保暖做得好,能有效預防寒邪和濕邪入侵,避免引發後續疾病。


浴室防滑的重要性

根據國民健康署統計,每年有336萬人因滑倒受傷就醫,其中意外超過
80%發生在家中浴室。
65%兒童意外皆發生在家中,5歲以下幼童腳部肌耐力不足容易在浴室滑 倒摔傷,
65歲以上年長者曾跌倒的比例為1/6,嚴重傷勢恐導致長期臥床甚至死亡。
因此打造防滑浴室,特別重要。


保溫地磚高於法規的防滑值


INAX 保溫地磚經測試,防滑係數皆達 0.96-1.20。
目前國家標準尚無適合可行之陶瓷面磚防滑性能量測 標準,經濟部標準檢驗局於98年7月29日(參照日本JIS A1509-12)制訂公布CNS 3299-12(陶瓷面磚試驗法第12部-防滑性試驗法),測得人行走於鋪設陶瓷面磚 之潮濕地面,穿鞋時的防滑係數C.S.R值和赤腳時的防
滑係數C.S.R-B值,數值越高則代表面磚防滑程度佳。
保溫地磚表面


浴室用的“浴室地板”:
保溫地磚地板類型
浴室地板類型為不平整凸面,即使腳濕也不易滑倒。
具有可用於大型公共浴室的【

洗手間/浴室空間:
保溫地磚內地板/ 壁式
內地板/牆壁類型為表面較為水平形狀,易於擦拭和清潔;即
使在乾燥的地面狀況,穿著襪子走在瓷磚上也不會被夾住。



細菌、污垢及氣味的產生機制


水周圍黏土的產生機理:
細菌會附著在汙垢等營養物質上,細菌的代 謝物變得黏稠,污垢會吸收有機物、鐵鏽、 細菌等,並且越來越膨脹。

廁所污垢和氣味的產生機制:
附著在馬桶和小便池上的細菌會分解 尿液中的尿素,產生氨和尿結石,這
種尿結石污漬成為溫床,因而造成細 菌進一步生長。

抗菌與未抗菌製品的比較
與沒有抗菌加工過的製品表面相比,細菌的增殖比率在百分之一以下,INAX保溫地磚
經過抗菌加工後,表面的細菌繁殖得到有效的抑制。



●日常保養,請使用浴室用弱鹼性清潔劑,用柔軟刷子擦洗,並使用足量的水洗去洗滌劑成分,盡量不要留水, 以免污漬附著在使用環境上。

●尤其是黑色、棕色等深色瓷磚,皮脂、洗髮水、護髮素等乾燥後的產品會變成白色污漬,很容易引起著色,要 經常保養。
污垢難以清除時的維護
●如果難以去除皮脂、洗髮水等白色污漬,漂白水時,請使用弱鹼性清潔劑和柔軟刷子清洗。避免使用強力去污 海綿刮去污垢。請注意,研磨性清潔劑和海綿可能會損壞瓷磚。
●染髮劑等附著時,請用含氯漂白劑和刷子或海綿擦洗,然後用大量清水沖洗
● 大浴場使用時,如果瓷磚上殘留皮脂污漬或皂垢,可能因滑倒導致嚴重受傷。請進行適當的維護以防止事故。

● 請避免使用含有顆粒的清潔劑或是刷具,若使用在浴缸、金屬製品、瓷磚、大理石等樹脂製品可能會造成划痕, 使用前請在不顯眼的地方檢查,使用電動拋光機時,請勿使用帶有研磨顆粒的墊子,瓷磚表面會磨損並降低止滑 效果。
● 將水灑在地磚上,灑上浴室清潔劑,用無紡布尼龍刷或電動拋光機擦至出現氣泡,靜置2~3分鐘左右,然後用 大量清水沖洗乾淨。
● 如果洗滌後仍有粘膩感,請塗抹含氯漂白劑並揉搓。揉搓後,用大量清水沖洗。
● 清洗後,用手觸摸,確保沒有粘膩感,沒有殘留洗滌劑。



IFT-300/HNK-31


IFT-300/HNK-32
IFT-300/HNK-33


IFT-300/SL-31N

IFT-300/SL-34N

IFT-300/SL-33N

IFT-300/SL-35N



IFT-300/QZ-31

IFT-300/QZ-32

IFT-300/QZ-34

IFT-300/QZ-33




IFT-300/ST-31N


IFT-300/ST-33N
IFT-300/ST-32N
















INAX Sanitary Ware Co., Ltd.